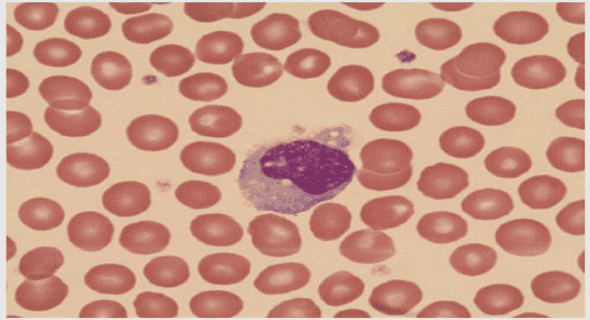

(Downloads - 0)
For more info about our services contact : help@bestpfe.com
Table of contents
1 INTRODUCTION
1.1 BACILLARY DYSENTERY
1.1.1 CLINICAL MANIFESTATIONS, COMPLICATIONS AND TRANSMISSION
1.1.2 EPIDEMIOLOGY
1.2 SHIGELLA SPP
1.2.1 SHIGELLA CLASSIFICATION
1.2.2 EVOLUTION OF SHIGELLA
1.2.3 SHIGELLA VIRULENCE PLASMID
1.3 OVERVIEW OF SHIGELLA INVASION
1.3.1 ANATOMY OF THE INTESTINAL EPITHELIUM
1.3.2 SHIGELLA INVASION ROUTES OF THE INTESTINAL EPITHELIUM
1.4 THE SHIGELLA TYPE III SECRETION SYSTEM
1.4.1 THE SHIGELLA T3SS STRUCTURE
1.4.2 SHIGELLA T3SS EFFECTOR PROTEINS
1.5 MAIN PLAYERS OF THE CYTOSKELETON
1.5.1 ACTIN MONOMERS
1.5.2 ACTIN SEQUESTERING PROTEINS
1.5.3 SEVERING PROTEINS
1.5.4 ACTIN NUCLEATORS
1.5.5 CAPPING PROTEINS
1.5.6 CROSS-LINKING PROTEINS
1.6 ADHESION STRUCTURES
1.6.1 INTEGRINS
1.6.2 ADHESION FORMATION AND MATURATION
1.6.3 TALIN AND VINCULIN MOLECULAR CLUTCH
1.6.4 FORCE GENERATION AND MATURATION
1.7 ACTIN CYTOSKELETON REORGANIZATION BY BACTERIAL PATHOGENS
1.7.1 BACTERIAL ADHESION AND INTERNALIZATION STRATEGIES
1.7.2 E. COLI FIMH CATCH-BOND ADHESION
1.7.3 ZIPPERING: LISTERIA MONOCYTOGENES INVASION MECHANISM
1.7.4 ATTACHING AND EFFACING LESION PATHOGENS
1.7.5 SALMONELLA “TRIGGERED” INTERNALIZATION
1.7.6 SHIGELLA INVASION AND CYTOSKELETON REMODELLING
1.8 IPAA
1.8.1 IPAA VINCULIN BINDING SITES
2 RATIONALE OF THE PHD PROJECT
3 ARTICLE 1
3.1 OVERVIEW
4 ARTICLE 2
4.1 OVERVIEW
5 ARTICLE 3
5.1 OVERVIEW
6 DISCUSSION
6.1 IPAA VBS3 BINDING TO TALIN
6.2 VINCULIN SUPRA-ACTIVATION: A NOVEL INTERACTION MODE
6.3 FUNCTIONAL IMPLICATIONS OF VINCULIN SUPRA-ACTIVATION ON CELL ADHESION
6.4 IPAA VBSS ROLE DURING SHIGELLA INVASION
6.5 GENERAL CONCLUSION
7 REFERENCES